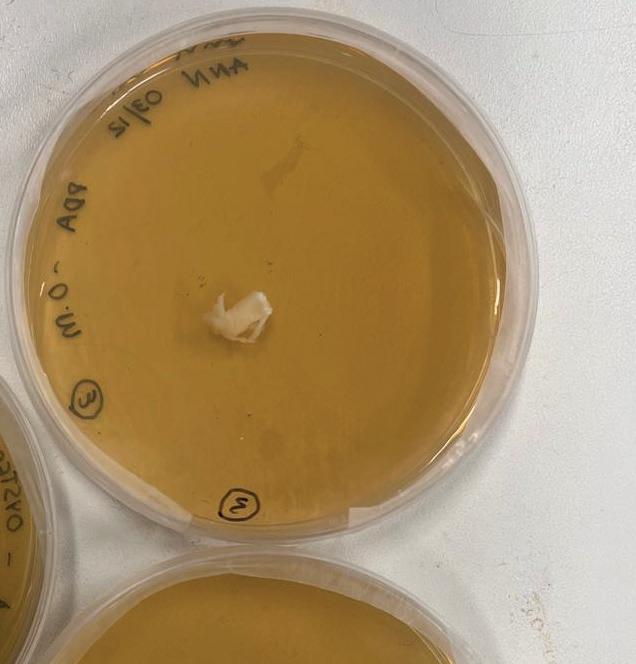

SUBMERGED FORESTS/ANN SAMUEL /27/01/2025/BARC0182
ABSTRACT
‘Submerged forests’ is a project to reconsider the ideas of Decay and Deterioration. Decay is a natural decomposition through the action of bacteria and fungi but deterioration refers to the process of an object slowly being impaired. Decay and deterioration in architecture is considered as the fall of utility and aesthetics of a building (Beech & Sunner, 2004). How can we use this natural process to create something constructive and better for the environment?
Wooden branches discarded usually due to their structural defects is used for this project. An aggregate system is created using these branches and joinery techniques. This structure when partially submerged into the river interacts with the velocity of water and primarily creates niches and pockets for aquatic species to habitat. Moreover, it helps with settlement of sediments and helps to enrich the river bed as the aggregate itself decays and settles into the river bed. This acts as a great way to practice carbon sequestration.
Cody Dock is a place built by a strong community and this same idea is taken into this project where a collaborative effort by the community acts as the base for the collection of wood, procurement and even designing each and every part of this bridge. The flexibility in design and stacking gives a sense of ownership for the people as they bring into bridge into life.

source: author

Mudflats and water serving as habitats for different organisms
CODY DOCK, 51.519164631106804, -0.0017588006810157085
“Our coastal and estuarine waters play a key role in the biogeochemical cycles that sequester and store carbon, known blue carbon.
Habitat restoration along intertidal rivers like the Lea can contribute towards the long term and large-scale efforts to restore these ecosystems, helping to sink carbon, and increase opportunities for biodiversity”
> Cody Dock Report 2021

Increases




3. Increases the

1. RIVERBED RESTORATION
Sedimentation of suspended sediment and particulate organic matter
2. DISSIPATING TURBULENCE
Allows fishes to move easily and settle into their habitats 3. SPATIAL HETEROGENEITY
Allows to create niches and habitats

Inspiration taken from works of Andrea Ling
DESIGN BY DECAY

Templating fungal growth, 2018. Chitosan, cellulose, vermiculite, brown rice, pink oyster mushroom spores.(Source: Andrea Ling)
A method of inoculating a concrete-like surfacing material with algae. If the algae can be kept alive, it can continuously sequester carbon.





Aguahoja, 2018. Upon exposure to rain water, the biopolymer pavilion will degrade programmatically, returning to the earth and fueling new growth;The Mediated Matter Group.
Allowing a system to decay


Testing different textures with water flow



source: author
PART THREE
MATERIAL EXPLORATIONS / LAB WORK
Wood surface area > Wood volume = Faster Decay
Wood surface area > Wood volume = More Microbial interaction
Lower oxygen concentration = Slower Decay

source: google images
LAB EXPLORATIONS
300 ml WATER
12g POTATO DEXTROSE AGAR

The studies conducted on decay of wood was an attempt to understand how wood interacts with water while being partially submerged in water.
The part of wood in contact with water did not show much fungal growth while the part of wood, wet but incontact with air showed fungal growth very quickly.While dry dead wood did not show any growth.
this helped us to conclude that the wood has to be partially submerged inorder to remain moist but in contact with air
GROWING WOOD DECAYING FUNGI
Growing fungi on wood helps the carbon sequestration process and allows the wood to have a more organic demise. This process also allows to create food opurtunities for smaller species. The idea of creating an ecosystem is acheived through this process.
EFFECT OF WOOD IN DIFFERENT SALINITIES




source: author


stacking the branches vertically


PHYSICAL PROTOTYPING
In the initial stage the branches were all considered to be the same size and stacked organically to achieve the desired structure. This exercise helped to understand the potential of these units and how they can be stacked in multiple axis. But this also showed how the units lacked a structural stability because the joinery was not very reliable.






source: author

Stacking the branches through minimal joinery was to see how efficient the units are on their own. However, after this exercise it was clear that the units needed a more formal joinery and assembly approach. This would allow the stacking to be more reliable and capable of holding the sturcture together.


































































































































JOINERY DETAILS




























































































































































GEOMETRY
INTERACTING WITH WATER





















































































































































































STACKING ITERATIONS














DENSITY AND DIVERSITY
































































































































































STUDYING DECAY USING COMPUTATIONAL ANALYS















SIMULATING DECAY ACCORDING TO THE DIRECTION OF WATER FLOW
HABITAT FOR AQUATIC SPECIES






























HABITAT FOR BIRDS





























HABITAT FOR FISHES STRUGLLING TO SURVIVE/ REPRODUCE







































HABITAT FOR FISHES


















































































































BIBLIOGRAPHY
1. Beech, I. B., & Sunner, J. (2004). Biocorrosion: towards understanding interactions between biofilms and metals.
2. Current Opinion in Biotechnology, 15(3), 181–186. https:// doi.org/10.1016/J.COPBIO.2004.05.001
3. Bekkering, J. D., Nan, C., & Schröder, T. W. A. (2021). Circularity and Biobased Materials in Architecture and Design. https://research.tue.nl/en/publications/circularityand-biobased-materials-in-architecture-and-design
4. Biopolymers for Responsive Architectural Scaffolds - Living Architecture Systems Group. (n.d.). Retrieved January 8, 2025, from https://livingarchitecturesystems. com/publication/biopolymers-for-responsive-architecturalscaffolds-rethinking-firmitas/
5. Celadyn, M., & Celadyn, W. (2022). Apparent Destruction Architectural Design for the Sustainability of Building Skins. Buildings, 12(8). https://doi.org/10.3390/ BUILDINGS12081220
6. Šerman, K., & Horvat, J. (2023). On the Phenomenon of Decay in Architecture. Prostor, 31(2(66)), 168–181. https:// doi.org/10.31522/P.31.2(66).3
7. Song, K. W., Bell, F., Deshpande, H., Mandel, I., Wun, T., Alistar, M., Buechley, L., Ju, W., Kim, J., Paulos, E., Sabie, S., & Wakkary, R. (2024). Sustainable Unmaking: Designing for Biodegradation, Decay, and Disassembly. Conference on Human Factors in Computing SystemsProceedings. https://doi.org/10.1145/3613905.3636300
8. Ellen Wohl. (2024). Ecosystem Benefits of Large Dead Wood in Freshwater Environments. In Oxford Research Encyclopedia of Environmental Science. Oxford University Press.